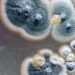
Pernambuco registra caso de fungo negro em paciente que teve Covid-19

Policiais Militares do 3º BPM, ao realizar operação conjunta entre ROCAM/3º BPM, GT 3211, RURAL/3º BPM, Guarda Municipal e vigilância sanitária, foram acionados para averiguar uma denúncia de descumprimento de decreto Estadual no bairro Ferro Velho.
Chegando ao local, o efetivo se deparou com um evento festivo, com aproximadamente 70 (setenta) pessoas. O proprietário da casa informou aos gritos que estava havendo um aniversário na residência, proferiu palavras de calão, tratou o policiamento de forma descortês e durante sua condução à Delegacia, ele fez ameaças ao efetivo e quebrou a fechadura do xadrez da viatura, danificando o patrimônio público.
Diante dos fatos, o homem foi apresentado na Delegacia de Polícia Local, onde foi lavrado um TCO em seu desfavor.
Siga o Instagram de Romero do Mais Pajeú: CLIQUE AQUI
Siga o Instagram do blog: CLIQUE AQUI
Siga nossa página no Facebook: CLIQUE AQUI
Siga nosso canal no YouTube: CLIQUE AQUI
Entra no nosso grupo no whatsapp: CLIQUE AQUI
Ajude o projeto Mais Pajeú a se manter: CLIQUE AQUI

Deixe seu comentário: